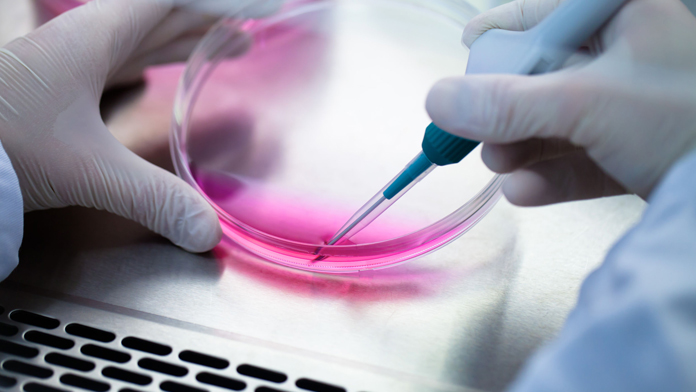

Trapianti
-

Trapianto di organi: tanti in attesa, poche le donazioni da vivente
È un’Italia a due velocità quella che si muove nel campo dei trapianti di organi. C’è l’Italia dell’eccellenza, che in…
Leggi tutto » -

Trapianto bilaterale delle mani: eccezionale risultato a Monza
È stato un successo di proporzioni mondiali il trapianto bilaterale di mani eseguito nella notte dell’11 ottobre del 2010 all’ospedale…
Leggi tutto » -

Trapianto di pene: il primo paziente operato sta per diventare padre
Prima l’amputazione obbligata, poi il trapianto di pene e ora la paternità. Nel giro di pochi anni la vita di…
Leggi tutto » -

Italiano il primo trapianto di femore con un omero
Ricostruito un femore con un omero da donatore a un bambino, colpito da un tumore raro, un osteosarcoma primitivo, che…
Leggi tutto » -
Trapianti: italiano il 1° paziente al mondo senza farmaci anti rigetto
Riduzione progressiva dei farmaci anti rigetto. È questa la direzione del protocollo sui trapianti. E il primo paziente trapiantato al…
Leggi tutto » -

Troppi interventi chirurgici negati agli over-75
«Povero vecchio, lasciamolo stare!». È questo l’atteggiamento che spesso prevale quando si tratta di decidere se operare un anziano con…
Leggi tutto » -

Aumentano i trapianti e i donatori in Italia
Aumentano i trapianti in Italia. Sono stati 3.317 i trapianti eseguiti in Italia nel 2015, 67 in più rispetto al…
Leggi tutto » -

Trapianti: gli organi da impiantare cresceranno nei maiali?
Cellule staminali umane iniettate all’interno di embrioni di maiali in modo da produrre delle cellule ibride, chiamate dagli scienziati chimera.…
Leggi tutto » -

Primo trapianto di pene negli Usa da donatore deceduto
Per la prima volta è stata effettuato un trapianto di pene da un donatore deceduto. Thomas Manning, 64 anni, bancario…
Leggi tutto »
